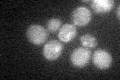

View description
Upstream serine/threonine kinase for the SNF1 complex; partially redundant with Elm1p and Tos3p; members of this family have functional orthology with LKB1, a mammalian kinase associated with Peutz-Jeghers cancer-susceptibility syndrome
Localization:
Intensity:
Fold change:
Significance:
-
C’ GFP library in SD

below threshold19.52 -
N' NOP1pr-GFP in SD

cytosol42.5874 -
N' TEF2pr-mCherry in SD

cytosol46.4039 -
N' NATIVEpr-GFP in SD

below threshold26.3895 -
N' TEF2pr-VC and Cyto-VN in SD

cytosol36.394 -
C’ GFP library in SD+DTT

cytosol16.990.87No -
C’ GFP library in SD+H2O2
cytosol22.121.13No -
C’ GFP library in Starvation Media

cytosol17.970.92No -
C’ GFP library on the background of Pup2-DaMP

below threshold -
C’ GFP library on the background of CCT mutant

below threshold18.92520.969224No
